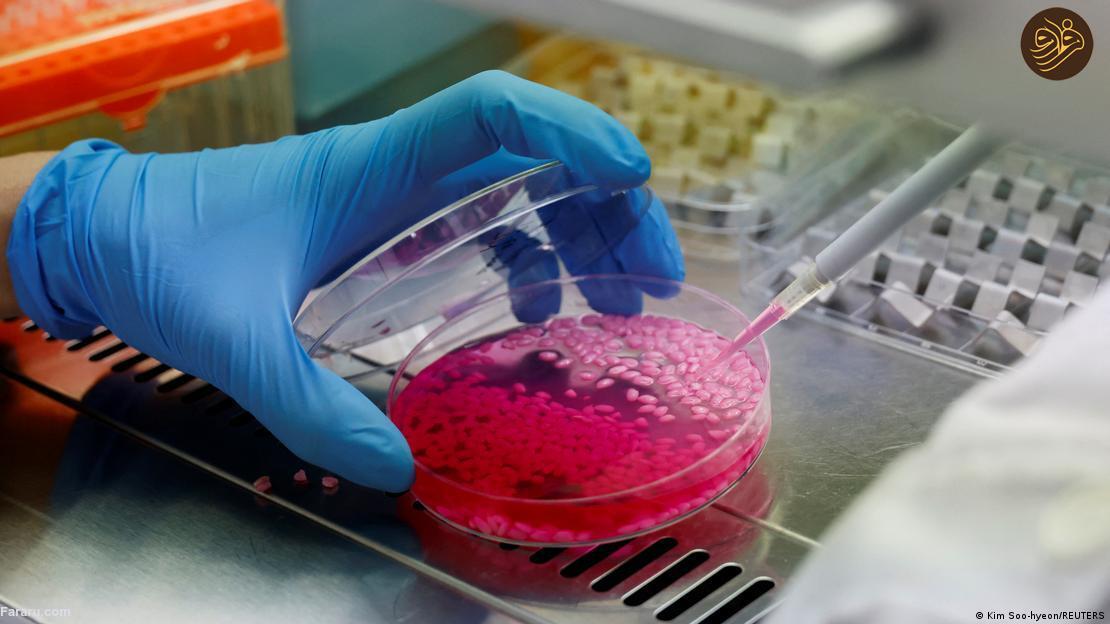
آیا برنج گوشت گاو آزمایشگاهی را می‌ خورید؟ / خوانده شد

برنج گوشت گاو آزمایشگاهی چه طعمی دارد؟
آیا این برنج عجیب را میخورید؟

محققان کره جنوبی اخیرا برنجی ترکیبی با سلول های گوشت گاو تولید شده در آزمایشگاه را خلق کرده اند آنان می گویند برنج گوشت گاو می تواند به منبع پایدار پروتئین تبدیل شود.
فرارو- پروتئین برای یک رژیم غذایی سالم ضروری است و شما میتوانید پروتئین خود را از گیاهان و حیوانات لوبیا، نخود، آجیل و دانههای غلات کامل و ماهی، مرغ و سایر دامها دریافت کنید. توصیه میشود که بخش عمده پروتئین مورد نیاز خود را از منابع گیاهی مصرف کنید. متخصصان میگویند گوشت قرمز مانند گوشت گاو "باید به صورت محدودتر مصرف شود". تولید گوشت از نظر زیست محیطی ناپایدار است.
به گزارش فرارو به نقل از دویچه وله، با این وجود، مصرف بیش از حد گوشت نیز میتواند منجر به بروز مشکلات سلامتی از جمله سرطان روده شود. اغلب این بیشتر به نحوه پختن گوشت مربوط میشود تا خود گوشت، اما هنوز هم باید در نظر داشت: به قول معروف شما همان چیزی هستید که میخورید. با این وجود، بسیاری از افراد از خوردن گوشت لذت میبرند. بنابراین، ایده پیوند یک برنج به عنوان یک پروتئین گیاهی با گوشت گاو پایدار و آزمایشگاهی باید خبر خوشایندی باشد. این چیزی است که دانشمندان در کره جنوبی میگویند که ایجاد کرده اند و آن را "برنج گاو" مینامند.
برنج گوشت گاو چیست؟
محققان در سئول در کره جنوبی گوشت و سلولهای چربی گاوها را با ژلاتین ماهی پوشانده و در دانههای برنج قرار دادند و در آنجا کِشت صورت گرفت. پوشش ژلاتینی به مواد مغذی از مواد حیوانی یعنی ماهیچههای گوشت گاو و سلولهای بنیادی چربی کمک کرد تا برنج رشد کرده و غنی شود. آن برنج به مدت ده روز در جریان یک کشت پرورش داده شد و به پروتئین و چربی سلولهای حیوانی اجازه رشد داد. آن چه حاصل شد یک دانه صورتی و سفید بود.
آیا طعم خوبی دارد؟
طعم اولیه عمدتا طعم برنج است. با این وجود، طعمهای پیچیده متعددی در هم تنیده شده اند. طعم پروتئینی تا حدودی مزهای آجیلی دارد و پس از آن طعمی خامهای و کرهای احساس میشود.

برنج گوشت گاو تا چه میزان مغذی است؟
برنج گوشت گاو آزمایشگاهی که به تازگی تولید شده حاوی ۸ درصد پروتئین بیشتر و ۷ درصد چربی بیشتر از برنج معمولی است. این امر باعث میشود آن ماده غذایی به منبعی غنی از اسیدهای آمینه ضروری تبدیل شود که پروتئین تولید میکند.
این ظرفیت بالقوه خود را به عنوان یک ابر غذای آینده نشان میدهد، اما هم چنین ایدههایی برای توسعه اشکال جدید محصولات غذایی هیبریدی ارائه میکند. با این وجود، برخی از کارشناسان مواد غذایی ارزش غذایی برنج گوشت گاو را زیر سوال برده اند.
محصول نهایی حاوی ۴.۸ گرم سلول گاو کشت شده بازای هر ۱ کیلوگرم برنج است. بدان معنا که ۰.۵ درصد محصول نهایی را گوشت کشت شده و ۹۹.۵ درصد را برنج تشکیل میدهد. برای جایگزینی گوشت پروتئین موجود در محصول نهایی باید بیشتر باشد. برنج گوشت گاو تنها یکی از چندین آزمایش برای اصلاح برنج با هدف وارد کردن مواد مغذی بیشتر به رژیم غذایی اصلی افراد است. برای مثال، برنج طلایی به گونهای مهندسی ژنتیک شده که حاوی نوعی ویتامین آ باشد که در رژیم غذایی برخی افراد در بخشهایی از آسیا و آفریقا وجود ندارد.
برنج گوشت گاو تا چه اندازه "سبز" یا سازگار با محیط زیست است؟
تیم کار کننده بر روی ایجاد برنج گوشت گاو اشاره کرد که کشت برنج هیبریدی توسط آنان گازهای گلخانهای کمتری نسبت به تولید پروتئین گوشت گاو معمولی منتشر میکند. آنان میگویند ۱۰۰ گرم پروتئین گوشت گاو حدود ۵۰ کیلوگرم دی اکسید کربن آزاد میکند در حالی که تولید ۱۰۰ گرم پروتئین از برنج هیبریدی کمتر از ۶.۲۷ کیلوگرم دی اکسید کربن آزاد میکند. در نتیجه، گوشت پرورشی به دلیل مزایای بالقوه آن برای محیط زیست، امنیت غذایی، پایداری و اخلاق حیوانی زمینهای بسیار امیدوار کننده است.
آن تیم اولین افرادی نیستند که بر روی محصولات گوشتی تولید شده در آزمایشگاه کار میکند. اولین برگر گوشت در آزمایشگاه در سال ۲۰۱۳ میلادی توسط "مارک پست" دانشمند هلندی رونمایی شد. کمتر از یک دهه بعد صنعت گوشت آزمایشگاهی به بیش از ۱۵۰ شرکت در سراسر جهان گسترش یافت. بخش عمده شرکتها بر تولید جایگزین برای گوشتهای معمولی مانند گوشت خوک، گوشت گاو و مرغ تمرکز کرده اند.
چرا خرید گوشت آزمایشگاهی دشوار است؟
گوشت تولید شده در آزمایشگاه هنوز برای تولید انبوه بسیار گران است و این بدان معناست که رساندن آن به قفسههای سوپرمارکتها دشوار میباشد. یکی از چالشهای اصلی آن است که گوشت تولید شده در ازمایشگاه برای رشد سلولها به محصولات حیوانی متکی باشد. در مطالعه اخیر محققان دستههای اولیه سلولهای ماهیچهای و چربی خود را از گاوهایی که در یک کشتارگاه محلی ذبح شده بودند به دست آوردند. همه گوشتهای آزمایشگاهی به سرم خون گاو به عنوان مکمل رشد متکی هستند.
این بهترین روشی است که ما برای رشد چنین سلولی در اختیار داریم تا بتوان با آن چیزی درست کرد. با این وجود، این روش بحثهای زیست محیطی و مسائلی را به همراه دارد از حمله موضوع ظلم به حیوانات و گران بودن. با این وجود، تولید کنندگان نیز راه دشواری برای متقاعد کردن افراد به خوردن گوشتهای کشت شده آزمایشگاهی دارند. نتیجه نظرسنجیای انجام شده در بریتانیا توسط آژانس استانداردهای غذایی نشان داد که تنها یک سوم از شرکت کنندگان مایل به آزمایش گوشت آزمایشگاهی بودند. تقریبا نیمی از شرکت کنندگان گزارش دادند که هیچ چیز نمیتواند آنان را تشویق کند تا گوشت آزمایشگاهی را امتحان کنند، اما بیش از یک چهارم گفتند که اگر بدانند خوردن آن بی خطر است میتوانند متقاعد شوند.













